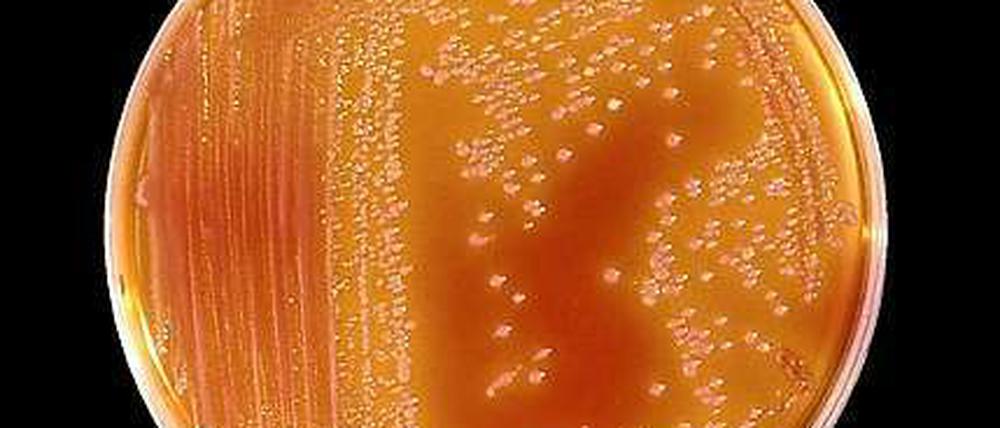
Serratia marcescens ist ein Keim, der überall vorkommt.

© dapd
Zustand eines zweiten Babys ist kritisch: Keime im Krankenhaus: Unsichtbare Gefahr
Einen perfekten Schutz gegen Keimbefall gibt es nicht. Doch an der Charité ist ein Baby gestorben, ein zweites schwebt nun in Lebensgefahr. Es stellen sich Fragen, die die Klinik und die zuständigen Politiker beantworten müssen.
Stand:
Lange galt Serratia marcescens als harmloser Zeitgenosse. Ein Keim, der überall vorkommt, im Erdreich wie auf Pflanzen, Tieren – und Menschen. Mittlerweile weiß man allerdings, dass er für Schwerkranke zur tödlichen Gefahr werden kann. Immerhin ein bis zwei Prozent aller Krankenhausinfektionen gehen auf Serratia zurück, und immer wieder kommt es zu Ausbrüchen in Kliniken. In Berlin ist nun ein Säugling nach einer Herzoperation möglicherweise an einer Infektion mit dem Mikroorganismus gestorben. Bei einem zweiten Kind ist der Zustand kritisch, es schwebt in Lebensgefahr. Insgesamt ist der Keim bisher bei rund zwei Dutzend Kindern auf Frühgeborenenstationen der Charité nachgewiesen worden, seine Quelle noch nicht entdeckt.
Hätte die Infektionswelle vermieden werden können? Man kann sich die Antwort leicht machen und sagen: Ja, natürlich. Jede Ansteckung durch einen Keim im Krankenhaus ist eine Folge unzureichender Hygiene, also von Schlamperei. In einer Klinik, in der perfekte Sauberkeit herrscht, dürfte es auch keine Krankenhausinfektionen geben.
Aber so eine Klinik gibt es nicht. Auch dort, wo ein hoher Hygienestandard herrscht, kommen Ansteckungen vor. Jedes Jahr stecken sich in Deutschland etwa eine halbe Million Menschen im Krankenhaus mit einem Erreger an, 10 000 bis 15 000 sterben an der Infektion. Zumindest ein Drittel der Todesfälle wäre jedoch nach Expertenmeinung vermeidbar, etwa durch mehr Sorgfalt bei der Hygiene.
Meist trifft es Menschen, deren Abwehrsystem geschwächt oder noch nicht richtig entwickelt ist, wie bei den Frühchen auf den Neugeborenenstationen der Charité. Bei vielen von ihnen hängt das Leben am seidenen Faden. Ein Keim, der einem Gesunden nicht das Geringste anhaben kann, wird für sie zur tödlichen Gefahr. Umso größer ist die Verantwortung des Personals, diese unsichtbare Gefahr stets zu gewärtigen, trotz aller Routine nicht leichtfertig zu werden.
Wo kommen die Keime vor?
Serratia-Keime mögen es feucht, vermehren sich häufig in Badezimmern, auf Fugen, in Toiletten und Seifenlösungen. Ein verkeimter Seifenspender könnte also die Ursache sein, auch verunreinigte Infusionslösungen haben schon Serratia-Ausbrüche ausgelöst. Am Ende kann aber auch eine unzureichende Desinfektion der Hände die Mikroben übertragen haben, also Sorglosigkeit der Auslöser sein. Die Charité muss alles daransetzen, die Ursache zu finden, und sie muss eine verunsicherte und beunruhigte Öffentlichkeit gründlich und offen über die Situation und die weitere Entwicklung informieren. Wer sich in Schweigen hüllt, erzeugt dagegen Misstrauen, weil er den Eindruck erweckt, als hätte er etwas zu verbergen – auch wenn das vielleicht gar nicht der Fall ist.
Offenbar ist die Gefahr im Augenblick halbwegs gebannt, die Keime lassen sich mit Antibiotika gut bekämpfen. Doch in jedem Fall stellen sich Fragen, die die Klinik und die zuständigen Politiker beantworten müssen. Warum wurde so lange gewartet, ehe man auf die Infektionswelle reagierte? Was hat es zu bedeuten, wenn der Gesundheitssenator sagt, es sei der Eindruck entstanden, die Charité komme mit der Lösung des Problems allein nicht weiter? Haben am Ende Kostendruck und Personalabbau ihren Anteil an dem tödlichen Hygieneproblem? Die Antworten sind wichtig, nicht zuletzt, um sich in Zukunft besser gegen den unsichtbaren Feind zu wappnen. Auch wenn es einen perfekten Schutz niemals geben wird.
- showPaywall:
- false
- isSubscriber:
- false
- isPaid: